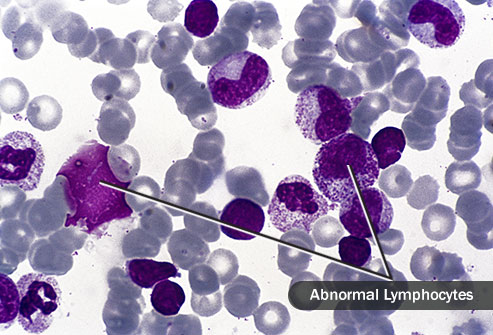
淋巴瘤e.jpg

淋巴瘤有可能被治愈嗎?帶著問題來看淋巴瘤的治療
醫(yī)學(xué)資訊
|
閱讀量:次
近年來,有一種惡性腫瘤在國內(nèi)外特別是發(fā)達(dá)地區(qū)的發(fā)生率持續(xù)上升,已經(jīng)超過白血病成為最常見的淋巴造血系統(tǒng)惡性疾病,這種疾病被統(tǒng)稱為淋巴瘤。
除了少數(shù)幾種與病毒或細(xì)菌相關(guān)的淋巴瘤類型以外,大部分淋巴瘤的發(fā)病原因尚不清楚,但推測與機(jī)體免疫和環(huán)境污染的關(guān)系密切。
臨床工作上,患者問得最多的一個(gè)問題就是:“我得的淋巴瘤有可能被治愈嗎?”
“當(dāng)然有可能”。
當(dāng)然,作為一種惡性腫瘤來說,其診治永遠(yuǎn)不會(huì)是簡單和一帆風(fēng)順的。
與其他常見的惡性腫瘤如肺癌、腸癌或者乳癌不同,淋巴瘤作為一種全身系統(tǒng)性疾病,其治愈手段并不依賴于外科手術(shù),而主要通過化療。
同樣也與其他腫瘤不同的是,淋巴瘤其實(shí)是一大類疾病,其包含了數(shù)十種不同的亞型,而每一種亞型往往又具有獨(dú)特的臨床及病理特征、治療方案和預(yù)后。
因此,對(duì)于淋巴瘤具體類型的診斷顯得至關(guān)重要,因?yàn)樵\斷錯(cuò)誤往往會(huì)導(dǎo)致治療失當(dāng)。
幸運(yùn)的是,淋巴瘤是一種對(duì)化療非常敏感的疾病,其治愈率總體上要超過前述的其他惡性腫瘤。隨著治療的進(jìn)步,淋巴瘤的兩大類型——霍奇金和非霍奇金淋巴瘤,其5年生存率大體上分別可以達(dá)到85%和65%的水平,而5年生存率是我們衡量腫瘤是否痊愈的關(guān)鍵標(biāo)志。
因此無論對(duì)于醫(yī)生、患者及其家屬來說,我們有什么理由對(duì)這一疾病采取悲觀或消極的態(tài)度呢?
淋巴瘤的首次治療
除了診斷以外,淋巴瘤的治療特別是首次治療顯得至關(guān)重要。

近年來,隨著新藥的不斷問世,淋巴瘤中相對(duì)預(yù)后較差的非霍奇金淋巴瘤的治療有了很大的提高,在這里不得不提到美羅華這一靶向藥物所作的貢獻(xiàn)。美羅華作為一種單克隆抗體藥物,其主要通過與B淋巴細(xì)胞表面的CD20抗原進(jìn)行特異性結(jié)合從而達(dá)到選擇性殺傷淋巴瘤細(xì)胞的作用。
作為一個(gè)已經(jīng)在國內(nèi)上市超過10年的經(jīng)典藥物,它已經(jīng)顯著提高了占非霍奇金淋巴瘤絕大多數(shù)的B細(xì)胞淋巴瘤的治療效果。
目前,美羅華今年已經(jīng)進(jìn)入了全國的醫(yī)保目錄,并且價(jià)格也有很大幅度的下降,預(yù)計(jì)會(huì)有更多的B細(xì)胞淋巴瘤患者得以從中獲益。
當(dāng)然并不是所有的淋巴瘤類型都是可以治愈的,比如某些低度惡性如濾泡性淋巴瘤或慢性淋巴細(xì)胞性白血病,但這些類型大多進(jìn)展緩慢并且治療效果較好。
淋巴瘤治療的變化
近年來,腫瘤的治療理念已經(jīng)有了革命性的改變,從以往同腫瘤細(xì)胞你死我活的斗爭理念逐步轉(zhuǎn)變?yōu)榭刂颇[瘤生長與瘤共存的治療理念。因此,對(duì)于患有不可治愈淋巴瘤的患者而言,首先要改變對(duì)于疾病的認(rèn)識(shí),樹立正確的觀念,做好長期與腫瘤做斗爭的心理準(zhǔn)備。
目前淋巴瘤的治療方法已經(jīng)有了翻天覆地的變化,傳統(tǒng)的化療藥物已經(jīng)逐步被分子靶向治療所替代,治療毒性大為降低,甚至在某些淋巴瘤類型中靶向治療已經(jīng)替代化療成為一線的標(biāo)準(zhǔn)治療。
因此,即便得了不可治愈的淋巴瘤也不要盲目地悲觀厭世,要相信現(xiàn)代醫(yī)學(xué)的進(jìn)步,很多患者都能夠從治療中達(dá)到長期生存甚至預(yù)期壽命的目的。
在過去的3-5年間,免疫治療的進(jìn)步已經(jīng)席卷了包括淋巴瘤在內(nèi)的多種腫瘤,被譽(yù)為未來腫瘤治療的主導(dǎo)。
免疫治療的實(shí)質(zhì)就是調(diào)動(dòng)人體自身的免疫細(xì)胞攻擊腫瘤細(xì)胞,這就好比我們得了感冒即便不用任何藥物過一段時(shí)間也可痊愈是同樣的道理,這就是自身免疫對(duì)抗流感病毒的作用典范。

由于免疫治療會(huì)特異性地攻擊腫瘤細(xì)胞而對(duì)正常細(xì)胞的影響輕微,因此免疫治療的毒性較化療甚至是靶向治療大為降低。舉例來說,有一種被稱為PD-1的藥物在復(fù)發(fā)的霍奇金淋巴瘤治療中取得了顯著的療效,目前正在應(yīng)用于一線治療中,有望徹底改變這一淋巴瘤的治療策略。
淋巴瘤的復(fù)發(fā)
不可否認(rèn),只要是惡性腫瘤就存在疾病復(fù)發(fā)的困擾。雖然我們可以通過疾病本身的一些危險(xiǎn)因素來判斷復(fù)發(fā)風(fēng)險(xiǎn),但對(duì)于個(gè)體來說,關(guān)鍵還是要加強(qiáng)隨訪,用時(shí)間來驗(yàn)證遠(yuǎn)期治療效果。
在復(fù)發(fā)風(fēng)險(xiǎn)最高的前2年,患者一般每3月進(jìn)行1次門診隨訪,進(jìn)行一些相關(guān)的檢查;從第3年起延長間隔,一旦滿了5年沒有復(fù)發(fā),腫瘤基本上治愈了。
當(dāng)然臨床上也有5年后復(fù)發(fā)的病例,但一般比例不會(huì)超過5%,另外也與某些特別的淋巴瘤類型有一定的關(guān)系。
好醫(yī)友提醒:在治療后的康復(fù)期內(nèi),還要注意觀察與腫瘤復(fù)發(fā)有關(guān)的一些癥狀如不明原因的發(fā)熱、盜汗、體重下降、持續(xù)性疼痛或者淋巴結(jié)腫大等,及時(shí)到醫(yī)院就診。另外還要說明的是,即便腫瘤復(fù)發(fā)了,仍然還是有治愈的機(jī)會(huì),目前新藥的發(fā)展十分迅速,不要輕言放棄。
2020-08-21 10:54
好醫(yī)友小編
聯(lián)系醫(yī)學(xué)顧問
醫(yī)學(xué)顧問微信在線